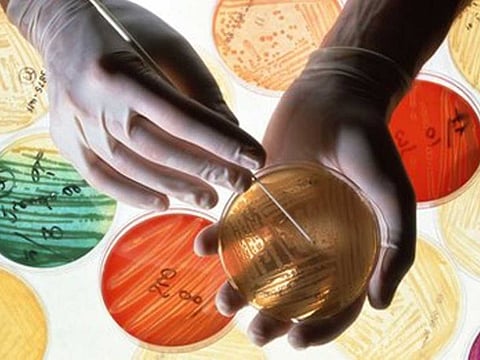
Supplied

World leaders to pledge action to prevent overuse of antibiotics as medical options are waning
DUBAI: For decades, public health experts have warned of the dangers of “superbugs”, microbes that can’t be stopped with drugs. Now, for the first time, world leaders are tackling the problem in earnest.
For only the fourth time, the world’s decision makers are addressing a health issue at the UN General Assembly. The others were the HIV/AIDS crisis (in 2001); chronic illnesses, such as heart attacks, stroke, diabetes and cancers (2011); and the Ebola epidemic (2014).
Wednesday’s meeting underscores the growing awareness by governments as well as disease experts that drug resistance is not just a health problem but an enormous economic and security threat. It’s also an international threat, because drug resistance spreads easily across species and throughout the world, observing no political boundaries.
“There’s a recognition now by different people, different sectors and different organisations that we are, in fact, dealing with an enormous challenge beyond a health issue alone,” said Keiji Fukuda, who oversees antimicrobial resistance at the World Health Organisation. “It doesn’t happen very often for health issues.”
On Monday, the World Bank said drug-resistant infections could cause global economic damage comparable to the 2008 financial crisis. Under a worst-case scenario, the bank projects that low-income countries could lose more than 5 per cent of their GDP and that up to 28 million people, mostly in developing countries, could be pushed into poverty by 2050.
Without changes in policies to combat drug resistance, an estimated $100 trillion (Dh368 trillion) in economic output could be put at risk by 2050, according to a separate analysis by an independent British commission chaired by Jim O’Neill, a former Goldman Sachs chief economist.
On Tuesday, in a rare case of collaboration among competitors, 13 leading pharmaceutical companies, including AstraZeneca, GlaxoSmithKline and Sanofi, presented a road map laying out several commitments they pledge to deliver by 2020 to reduce drug resistance.
The companies said they will work with their manufacturers and suppliers to cut the environmental footprint from antibiotic production; monitor company promotional activities and share surveillance data as a way to reduce unnecessary antibiotic use; improve access to current and future antibiotics, vaccines and diagnostics; and explore new public-private collaborations for research and development.
Issue and consequences
Antimicrobial resistance refers to infections that have evolved the ability to withstand drugs that ought to stop them. The medicines include antibiotics, which act on bacteria, as well as drugs to fight fungal, viral or parasitic infections. If these life-saving medicines are rendered ineffective by multidrug-resistant superbugs, even the most minor infections would be untreatable, bringing back a level of danger not seen since the 19th century.
An estimated 700,000 people die every year from drug-resistant infections already, according to the WHO. Without policies to halt the spread of this resistance, the toll could soar to 10 million additional deaths annually by 2050, or one person every three seconds, according to the British commission review. That’s more than the number of people now killed each year by cancer.
World leaders are issuing a call to action to reduce inappropriate use of antimicrobial medicines in humans, restrict the routine use of antibiotics to boost growth in farm animals, improve access to better diagnostics, and jump-start the development of new drugs.
In the US, for example, nearly a third of antibiotics prescribed in doctors’ offices, emergency rooms and hospital-based clinics are not needed and not effective, according to a recent in-depth study.
The widespread use of antibiotics in animals encourages development of resistant microbes that can spread to humans and then withstand drug treatments. Many of the same drugs are used in people and livestock, with more than 70 per cent by weight of those antibiotics going to animals.
What experts say
Some experts want the UN to set global targets for reducing the use of antibiotics to encourage livestock to grow faster, a sensitive topic. Banning the use of such drugs would drive up meat costs when the world demand for protein is growing.
“If you want to solve these problems, you need targets and a kind of accountability mechanism to make sure countries do what they say,” said Ramanan Laxminarayan, an infectious disease researcher who directs the Centre for Disease Dynamics, Economics & Policy.
The draft resolution being considered at the UN, however, does not include such specifics, a weakness that Laxminarayan called “disappointing”.
Still, he and other experts said they are encouraged that the issue is getting high-level attention.
The hope is that public agreement by senior leaders will help trigger action among officials and researchers in their home countries, said Allan Coukell, senior director for health programmes at The Pew Charitable Trusts, which has a project tracking antibiotic resistance.
Experts say the political momentum for the meeting has been developing in recent years. After hospitals were forced to close in Ghana because of superbug threats, Ghana’s health minister co-sponsored a forum on antimicrobial resistance four years ago. The Obama administration announced a national action plan to combat superbugs last year, and established a presidential council to combat antibiotic-resistant bacteria.
At the World Economic Forum in Davos in January, more than 80 international drug and biotech firms urged governments to work with the industry to cut unnecessary use of antimicrobial drugs and support development of new antibiotics and invest in research. Earlier this summer, leaders of the G7 industrialised countries said resistance is an international priority.
The problem of pathogens becoming drug resistant has been recognised since shortly after the discovery of penicillin in 1928. The problem has worsened drastically because drug companies have cut their investment in new drugs, so microbes have had plenty of time to evolve resistance to the old ones. It’s been more than 30 years since a new class of antibiotic has been introduced. Experts point to scientific barriers to discovery, regulatory hurdles and diminishing returns on investment for drug companies.
Multilayered strategy
In a bluntly worded report, the O’Neill commission suggests a “pay or play” strategy as one way to incentivise drug companies in the race to develop new antibiotics. Companies should be subject to a surcharge if they decide not to invest in research and development. Those who decide to “play” should get a reward of between $1 billion and $1.5 billion for any successful new antimicrobial medicine brought to market.
Meanwhile, superbug outbreaks are spreading around the world. The newest superbug, resistant to an antibiotic called colistin, has been detected in nearly 30 countries since its discovery was reported in China a year ago. Colistin is known as the antibiotic of last resort because many infections that are resistant to every other drug do still respond to colistin.
The gene for colistin resistance, known as mcr-1, has been found in at least four people in the US, including a Connecticut toddler. The worst-case scenario would be if the gene, which spreads easily, jumps into other bacteria that can already evade most antibiotics, creating a kind of uber-superbug.
Experts say the biggest challenge will be to raise awareness and spur action from government leaders down to individuals. But that’s difficult. Many people don’t think their individual actions are adding to the problem.
“If you talk to any individual physician around the world, they all definitely agree that drug resistance is a big problem,” said Laxminarayan. “But they are not the ones who overprescribe. It’s always someone else.”